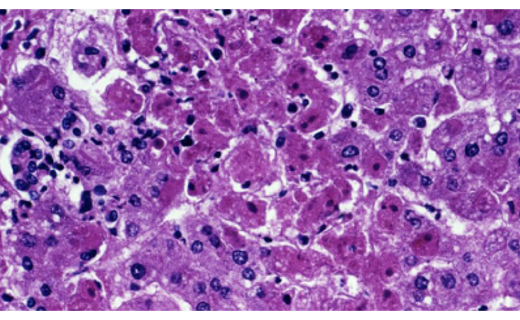

#ADGHW In the News
Healthcare Industry News


Poor spatial navigation 'could predict Alzheimer’s disease decades before memory loss'


Overweight, not just obesity, drives higher healthcare costs, Norwegian study finds